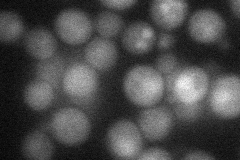
YBR105C
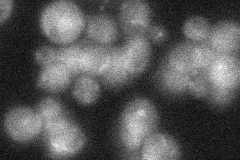
YBR105C
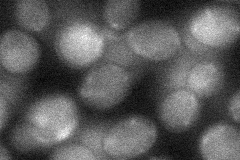
YBR105C
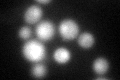
YBR105C
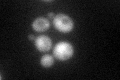
YBR105C

View description
Peripheral membrane protein located at Vid (vacuole import and degradation) vesicles; regulates fructose-1,6-bisphosphatase (FBPase) targeting to the vacuole; promotes proteasome-dependent catabolite degradation of FBPase
Localization:
Intensity:
Fold change:
Significance:
-
C’ GFP library in SD

nucleus:cytosol58.91 -
N' NOP1pr-GFP in SD

cytosol43.9156 -
N' TEF2pr-mCherry in SD
cytosol30.3631 -
N' NATIVEpr-GFP in SD
below threshold18.1117 -
N' TEF2pr-VC and Cyto-VN in SD
below threshold28.8156 -
C’ GFP library in SD+DTT
nucleus.cytosol53.110.9No -
C’ GFP library in SD+H2O2
nucleus.cytosol14.890.87No -
C’ GFP library in Starvation Media

nucleus,cytosol36.870.62No -
C’ GFP library on the background of Pup2-DaMP

nucleus:cytosol -
C’ GFP library on the background of CCT mutant

nucleus:cytosol53.14820.902018No
